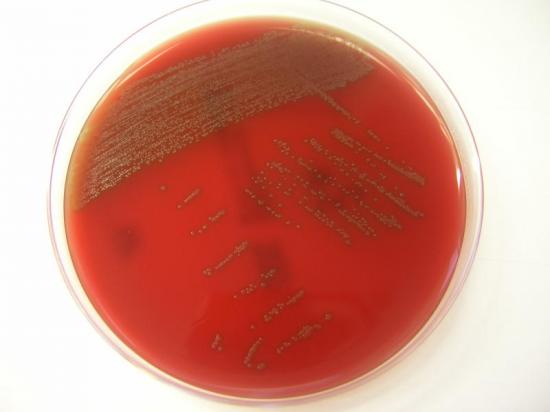

导读:近日,来自瑞士苏黎世大学的研究者在口腔中发现了一种常见细菌,这种细菌如果进入血液有可能导致严重的疾病。这种细菌名为S.tigurinus,常见的牙龈出血会给这种细菌进入血液进而造成严重的感染提供便利的途径。
近日,来自瑞士苏黎世大学的研究者在口腔中发现了一种常见细菌,这种细菌如果进入血液有可能导致严重的疾病,这项研究成果刊登在了近日的国际杂志The International Journal of Systematic and Evolutionary Microbiology上,这项新的研究发现将有助于科学家研究这种细菌是如何致病的,并且可以评估这种细菌的致病风险。
研究者发现的这种细菌命名为Streptococcus tigurinus(S.tigurinus,链球菌属的某种细菌),S.tigurinus是从心内膜炎、脑膜炎、脊椎关节炎病人的血液中分离出来的,和链球菌属的其它细菌有很高的相似性,都可以在口腔中繁殖,常见的牙龈出血会给这种细菌进入血液进而造成严重的感染提供便利的途径。 领导此项研究的研究者Andrea Zbinden博士表示:“S.tigurinus的识别对于临床上治疗非常重要,精确地识别、研究该细菌对于追踪该细菌的分布、以及感染机制、途径都非常有必要,而且可以为我们临床上寻扎合适的治疗药物进行治疗提供一定的线索。
研究者又表示,S.tigurinus的发现并不可怕,这种细菌的致病风险是可以估计的,而且有能力引起严重的感染疾病,下一步,我们研究的重点是解释S.tigurinus在口腔中为什么是如此普遍,以及S.tigurinus的致病风险,免疫抑制、异常的心脏瓣膜感染以及慢性感染等都很有可能是因为S.tigurinus进入血液产生的感染所引起的。然而S.tigurinus特殊的感染因子(或感染机制)有待于进一步研究才能够解释。

Streptococcus tigurinus sp. nov., isolated from blood of patients with endocarditis, meningitis and spondylodiscitis
Andrea Zbinden1,5, Nicolas J. Mueller2, Philip E. Tarr3, Cathrin Spröer4, Peter M. Keller1 and Guido V. Bloemberg1
Four Gram-stain-positive, catalase-negative, coccus-shaped bacterial strains were isolated from multiple blood cultures of patients with endocarditis, meningitis and spondylodiscitis. The isolates were tentatively identified as viridans streptococcal species based on phenotypic characteristics. Comparative 16S rRNA gene sequencing studies showed that the organisms were members of the Streptococcus mitis group but did not correspond to any recognized species. The nearest phylogenetic relative was Streptococcus mitis ATCC 49456T with 98.6% sequence similarity. The representative strain AZ_3aT showed similarity values of less than 96.8%, 97.6%, 94.5% and 95.5% to the phylogenetically most closely related species by recA, rpoB, sodA and groEL gene sequence analysis, respectively. DNA-DNA hybridization analyses showed a low reassociation value of 32.2% between strain AZ_3aT and S. mitis DSM 12643T. Reassociation values with other S. mitis group species ranged from 27.3% to 49.7%. The G+C content of the DNA is 40.0 mol%. Based on our biochemical and molecular analyses, the novel isolates represent a new species, for which the name Streptococcus tigurinus sp. nov. is proposed. The type strain is AZ_3aT( =CCOS 600T =DSM 24864T).
文献链接:https://ijs.sgmjournals.org/content/early/2012/01/16/ijs.0.038299-0

